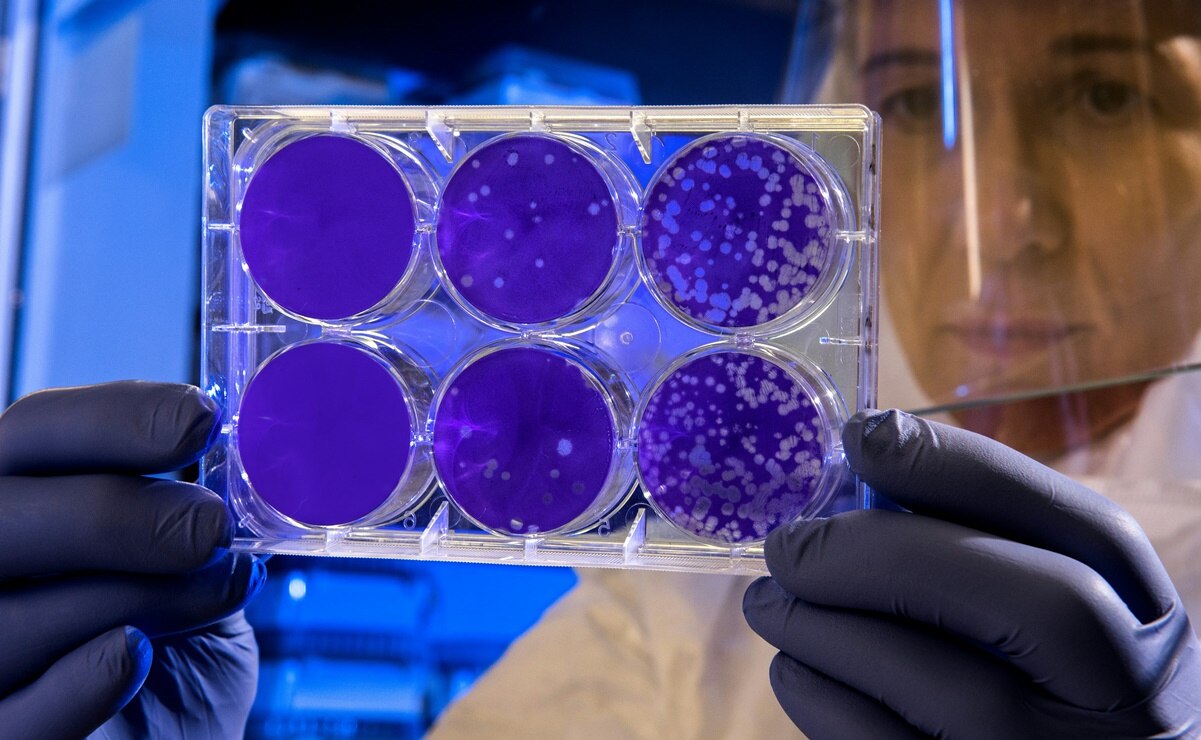
Un nivel alto de enterococcus fecalis revela las playas que no son aptas para las actividades recreativas. Foto: Unsplash.

Durante un análisis de la calidad del agua realizado por la Comisión Federal para la Protección contra Riesgos Sanitarios (COFEPRIS) y la Red Nacional de Laboratorios de Salud Pública (RNLSP), se examinaron 289 playas en los principales destinos turísticos de México. Este estudio, realizado para garantizar la seguridad durante las vacaciones de invierno 2024, incluyó la evaluación de 2,362 muestras de agua en busca de posibles contaminantes.
Playas de México no aptas para actividades recreativas en invierno 2024
Los resultados del análisis revelaron que, de las 289 playas revisadas, 283 playas fueron calificadas como aptas para actividades recreativas. Sin embargo, cinco playas presentaron niveles de contaminación que exceden los estándares de calidad, representando un riesgo para la salud de los turistas. Estas playas no cumplen con los requisitos de calidad establecidos por las autoridades sanitarias, y su uso recreativo está desaconsejado:
- Baja California: Playas Rosarito y Rosarito I. Tijuana y Tijuana I.
- Guerrero: Playa Icacos.
- Jalisco: Playa Oasis.
Lee más: Estos son los 5 hoteles más lujosos y exclusivos de San Luis Potosí
Bacterias peligrosas encontradas en las playas contaminadas
Entre las bacterias detectadas en las playas más sucias de México se encuentra Enterococcus faecalis, un indicador clave de contaminación que se encuentra en el tracto gastrointestinal de humanos y mamíferos. Esta bacteria puede causar diversas enfermedades, como gastroenteritis, salmonelosis, cólera, otitis, conjuntivitis y infecciones respiratorias y de la piel.
La COFEPRIS advierte que un nivel superior a 200 enterococos por cada 100 mililitros de agua representa un riesgo para la salud. Las autoridades exhortan a los vacacionistas a evitar las playas contaminadas para prevenir posibles infecciones y complicaciones de salud.

Cómo mantener las playas limpias y seguras
La COFEPRIS también destacó la importancia de la participación activa de turistas y locales en la conservación de las playas. Mantener los espacios naturales limpios es una responsabilidad compartida que ayuda a preservar el medio ambiente y garantiza la seguridad de todos.
Los turistas y ciudadanos pueden reportar cualquier irregularidad en la calidad del agua a los Comités de Playas locales o a través de las plataformas oficiales de COFEPRIS y la Secretaría de Medio Ambiente y Recursos Naturales (SEMARNAT).
Te interesa: Los Peroles, manantial de agua cristalina muy cerca de la capital de SLP
Monitoreo constante para un turismo responsable
El monitoreo continuo de la calidad del agua en las playas más visitadas de México es esencial para proteger la salud pública. La colaboración entre las autoridades sanitarias y la comunidad local es clave para asegurar que los destinos turísticos sigan siendo seguros y atractivos para los visitantes durante la temporada vacacional.
[Publicidad]
Más información

Metrópoli
Fan Fest del Mundial de Futbol 2026 podría mudarse a Plaza del Carmen de SLP, adelanta Galindo

Estado
Nombran a Nadia Ochoa como titular de la Coordinación Estatal de Protección Civil en San Luis Potosí

Seguridad
Localizan sin vida a Jazmín Maricela tras 18 días de búsqueda en San Luis Potosí

Metrópoli
VIDEO: Mal estado de animales en zoológico Tangamanga I desata preocupación; horas después personal lo atiende

























